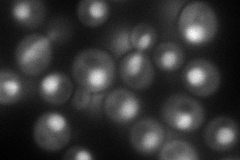

View description
Ubiquitin-specific protease that specifically disassembles unanchored ubiquitin chains; involved in fructose-1,6-bisphosphatase (Fbp1p) degradation; similar to human isopeptidase T
Localization:
Intensity:
Fold change:
Significance:
-
C’ GFP library in SD

nucleus22.28 -
N' NOP1pr-GFP in SD
nucleus143.588 -
N' TEF2pr-mCherry in SD

nucleus163.076 -
N' NATIVEpr-GFP in SD

nucleus35.5925 -
N' TEF2pr-VC and Cyto-VN in SD

#N/A0 -
C’ GFP library in SD+DTT

nucleus20.020.89No -
C’ GFP library in SD+H2O2

nucleus25.71.15No -
C’ GFP library in Starvation Media

nucleus21.270.95No -
C’ GFP library on the background of Pup2-DaMP

nucleus -
C’ GFP library on the background of CCT mutant

nucleus23.24261.0429No
